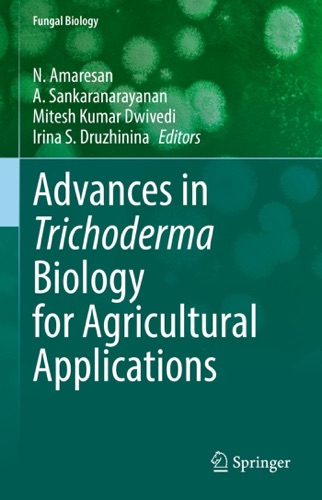

BookBucks
HOME
View All Genre
Book
- All Genres
- Arts and Entertainment
- Biographies and Memoirs
- Business
- Children and Teens
- Comics and Graphic Novels
- Communications and Media
- Computers and Internet
- Cookbooks, Food and Wine
- Fiction and Literature
- Health, Mind and Body
- History
- Humor
- Kids
- Lifestyle and Home
- Military and Warfare
- Mysteries and Thrillers
- Nonfiction
- Parenting
- Politics and Current Events
- Professional and Technical
- Reference
- Religion and spirituality
- Romance
- Sci-fi and Fantasy
- Science
- Sports
- Travel and Adventure
- Young Adult
Audiobook
- All Genres
- Arts and Entertainment
- Latino
- Biography and Memoir
- Business and Personal Finance
- Classics
- Comedy
- Drama and Poetry
- Erotica
- Fiction
- History
- Kids and Young Adults
- Languages
- Mystery and Thrillers
- News
- Nonfiction
- Religion and Spirituality
- Romance
- Sci-Fi and Fantasy
- Science
- Self Development
- Speakers and Storytellers
- Sports
- Technology
- Travel and Adventure